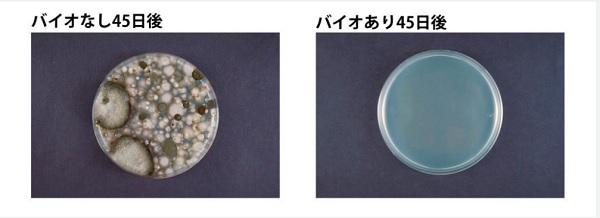

パワーバイオ 洗濯槽のカビきれい コジット 洗濯機 洗濯槽 強力洗浄 消臭 防カビ バイオ BIO 酵素 3包入り 新生活
1,450
酸素+酵素のチカラで洗濯槽を強力洗浄。
活性化したバイオが定着して、約45日間洗濯槽のきれいをキープしてくれる嬉しいアイテムです。
パワーバイオ 洗濯槽のカビきれい コジット 洗濯機 洗濯槽 強力洗浄 消臭 防カビ バイオ BIO 酵素 3包入り 新生活
活性化したバイオが定着して、約45日間洗濯槽のきれいをキープしてくれる嬉しいアイテムです。
パワーバイオ 洗濯槽のカビきれい コジット 洗濯機 洗濯槽 強力洗浄 消臭 防カビ バイオ BIO 酵素 3包入り 新生活
◆ パワーバイオ 洗濯槽のカビきれい ◆
酸素とバイオのチカラで強力洗浄・消臭・防カビ!
| 酸素+酵素のチカラで洗濯槽を強力洗浄。 活性化したバイオが定着して、約45日間洗濯槽のきれいをキープしてくれる嬉しいアイテムです。 |
| サイズ | 商品サイズ(パッケージサイズ)H14cm×W10.5cm×D3cm 本体サイズ50g×3包 |
| 素材・材質 | 成分/過炭酸ナトリウム、微生物(バチルス菌属)、酵素 |
| セット内容 | 3包 |
| 使用上の注意 | ●本品は食べられません。お子さまの手の届く場所に置かないでください。 ●万一誤って食べた場合はすぐに吐き出し、医師に相談してください。 ●洗濯物を入れたまま使用しないでください。 ●商品の仕様上、パウチに穴があいていますが、使用・保管には問題ありません。 ●開封後は1回で1包をすべて使い切ってください。 ●保管状況により固化・分離が生じることがありますが、使用には問題ありません。 ●効果持続期間は使用状況により異なります。 ●バイオは生き物です。環境によって活動が変化するため、効果が目に見えて現れてくる時期は状況によって異なります。 ●環境下に汚れや悪臭の原因となる物質などの有機物が異常に多い場合、効果を感じるのに時間がかかります。 ●バイオの効果に影響があるため、本品使用中にアルカリ性および塩素系などの薬剤、還元系漂白剤・洗浄剤はご使用にならないでください。 ●皮膚の弱い方は炊事用の手袋を使用してください。また、使用後は手をよく洗ってください。 ●本品の粉が舞って吸い込んでしまう恐れがありますので、飛び散りにはご注意の上、開封や投入の際、顔を近づけないようにしてください。 ●目に入った時は、直ちに十分な水で洗い流し、眼科医に相談してください。 ●皮膚についた時は、流水で洗い流してください。 ●直射日光のあたる場所や、高温多湿の場所を避け、冷暗所に保管してください。 ●本来の用途以外には使用しないでください。 |
| 生産国 | 日本 |
| メーカー | 株式会社コジット |